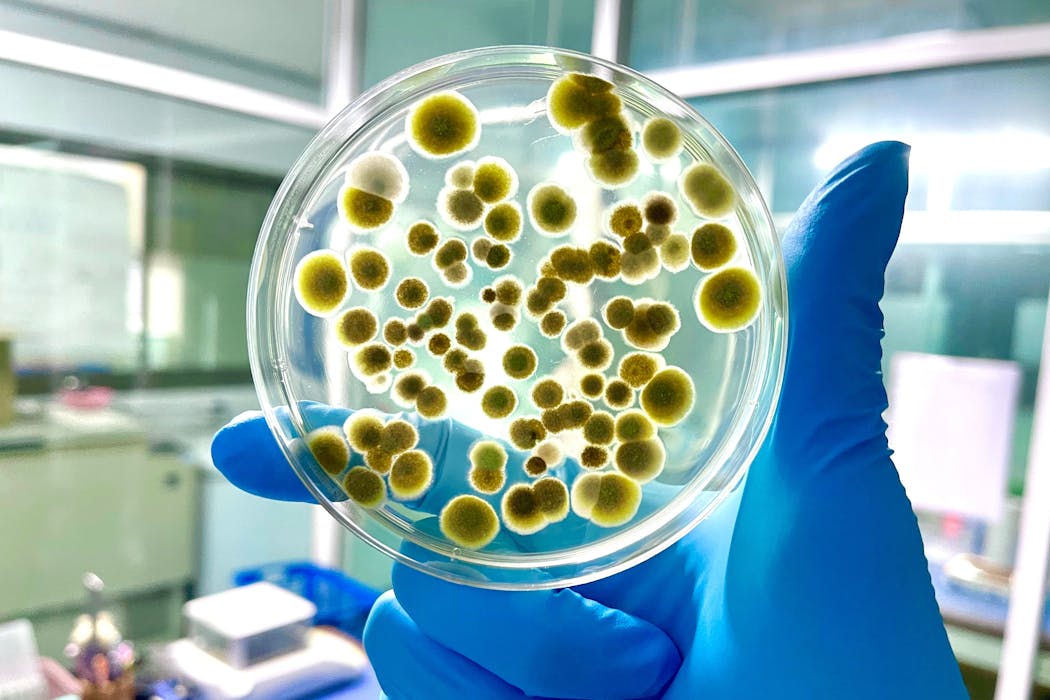

Source: The Conversation – (in Spanish) – By Ana Belén Ropero Lara, Profesora Titular de Nutrición y Bromatología – Directora del proyecto BADALI, web de Nutrición. Instituto de Bioingeniería, Universidad Miguel Hernández

Inscrita en la Lista del Patrimonio Cultural Inmaterial de la Humanidad de la UNESCO desde 2013, la dieta mediterránea es una parte esencial de nuestra cultura que, además, produce efectos beneficiosos en la salud. Pero su poder protector no reside en los hábitos alimentarios actuales o en los productos manufacturados en la región mediterránea. En realidad, proviene del patrón dietético clásico cuyos efectos han sido validados por decenas de estudios científicos con la participación de miles de personas.
Entonces, ¿a qué podemos llamar dieta mediterránea?
Según la definición de la UNESCO, “comprende un conjunto de conocimientos, competencias prácticas, rituales, tradiciones y símbolos relacionados con los cultivos y cosechas agrícolas, la pesca y la cría de animales, y también con la forma de conservar, transformar, cocinar, compartir y consumir los alimentos”. Por lo tanto, constituye también un patrón social.
De todos modos, el componente fundamental de este patrimonio cultural es, como su nombre indica, la dieta propiamente dicha. Para saber cómo de mediterránea es nuestra alimentación, debemos tener en cuenta 14 puntos. A mayor puntuación, más se le parece.
En primer lugar, los alimentos recomendados que suman puntos son:
-
El aceite de oliva.
-
Las verduras y hortalizas.
-
Las frutas.
-
Las legumbres.
-
El pescado y el marisco.
-
Los frutos secos.
-
La carne blanca (pollo, pavo, conejo).
-
El tradicional sofrito para acompañar platos principales.
Y los productos a evitar, los que nos alejan de la dieta mediterránea, son:
-
Las carnes rojas y procesadas.
-
La mantequilla, margarina o nata.
-
Las bebidas carbonatadas, ya sean azucaradas o no.
-
La repostería comercial.
Beneficios probados para la salud
El primer estudio sobre la dieta mediterránea se publicó en 1970, pero tuvieron que pasar aún más de 20 años para que volviera a despertar interés. Desde entonces ha sido foco de intensa investigación en nutrición.
Uno de los principales trabajos es español y en él participaron más de 90 investigadores. Se trata del estudio PREDIMED, diseñado para evaluar los efectos de este patrón alimentario en personas mayores con alto riesgo de enfermedad cardiovascular. Las conclusiones fueron inapelables: la incidencia de eventos cardiovasculares era claramente menor en los grupos de dieta mediterránea.
Ahora, después de décadas de investigaciones, los resultados no dejan lugar a dudas: la dieta mediterránea es una firme aliada para nuestra salud. Seguirla reduce el riesgo de mortalidad y de sufrir tres de las enfermedades más frecuentes de nuestro tiempo: las dolencias cardiovasculares, el cáncer y la diabetes tipo 2. Además, también protege contra el deterioro cognitivo, la demencia y el alzhéimer.
Menús poco mediterráneos
A pesar de todas estas evidencias, la realidad es que nuestra alimentación actual se parece poco o nada a la dieta mediterránea. Además, solemos creer erróneamente que alimentos muy consumidos, como el cerdo, el jamón o el queso, forman parte de ella.
Si echamos un vistazo a los 14 puntos mencionados en el estudio PREDIMED, leemos que uno de ellos es: “¿consume usted preferentemente carne de pollo, pavo o conejo en vez de ternera, cerdo, hamburguesas o salchichas?”. Para obtener un punto, la respuesta debe ser sí. Además, una de las recomendaciones adicionales es no tomar más de una ración de jamón curado o de carne roja a la semana.
La principal razón para esta restricción es que tanto el jamón curado como cualquier otro embutido son carnes procesadas, y estas aumentan las probabilidades de sufrir cáncer colorrectal, el segundo cáncer más mortal del mundo. Otra razón es su alto contenido de sal, que incrementa el riesgo de enfermedades cardiovasculares y renales.
Además, en términos de salud, el cerdo se clasifica como carne roja, un riesgo adicional para contraer el citado cáncer colorrectal. Por si fuera poco, tomar mucha carne roja y procesada también aumenta las posibilidades de morir por problemas cardiovasculares.
En lo que se refiere a los quesos, los bajos en grasa no tienen límites estrictos en la dieta mediterránea, mientras que los curados o grasos (la gran mayoría) están restringidos a un máximo de una ración semanal. Esto se debe a su elevado contenido de sal y a que predominan las grasas saturadas, dos riesgos considerables para la salud.
¿Vino sí o vino no?
Uno de los aspectos más controvertidos de la dieta mediterránea es el vino. Aunque puntúa positivamente en el estudio PREDIMED, no se fomenta su consumo, sino que se limita la cantidad a quienes ya son consumidores habituales.
El vino, particularmente el tinto, goza de buena fama por la presencia de polifenoles procedentes de la uva. De hecho, en el propio estudio PREDIMED se observó que tomar más polifenoles puede disminuir el riesgo de mortalidad. Sin embargo, estos compuestos naturales también se encuentran en alimentos muy consumidos, como el aceite de oliva virgen, los frutos secos, las frutas y las verduras.
Además, el vino no deja de ser una bebida alcohólica y la conclusión de la Organización Mundial de la Salud al respecto es que beber alcohol puede causar más de 200 problemas de salud. De hecho, esta institución considera que no hay un nivel que no suponga un riesgo, por bajo que sea.
Leer más:
“Yo no bebo mucho, bebo lo normal”
Lo positivo es que siempre estamos a tiempo de mejorar nuestra salud. No importa la edad a la que lo hagamos: cualquier momento es bueno para acercar nuestra alimentación a los 14 puntos de la dieta mediterránea. Cada paso que demos hacia un mayor cumplimiento de este patrón alimentario, por pequeño que sea, supone un beneficio en la prevención de enfermedades.
![]()
Las personas firmantes no son asalariadas, ni consultoras, ni poseen acciones, ni reciben financiación de ninguna compañía u organización que pueda obtener beneficio de este artículo, y han declarado carecer de vínculos relevantes más allá del cargo académico citado anteriormente.
– ref. Pautas para seguir una verdadera dieta mediterránea – https://theconversation.com/pautas-para-seguir-una-verdadera-dieta-mediterranea-266678